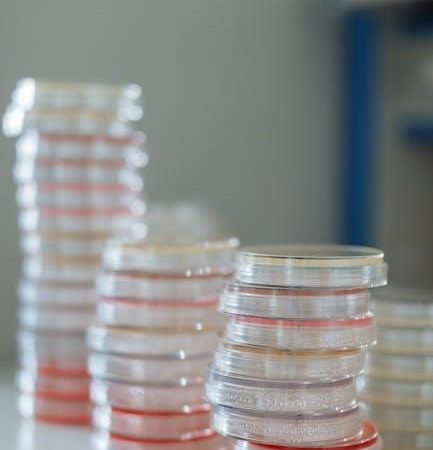
benson’s microbiological applications laboratory manual pdf

Ready to build your own awesome k’nex helicopter? Find clear, step-by-step instructions here and get ready for takeoff! Let’s build a helicopter!
Struggling with citing that lab manual in APA style? We’ve got you covered! Get a quick & easy guide to perfect **APA citation** with examples. Virtual PM helps!
Struggling with Form 911? Don’t sweat it! Our simple instructions break down everything you need to know. File confidently & save time. Get started now!
Find amazing free alto sax sheet music in PDF format! Huge selection for all levels – from beginner to pro. Start playing your favorite tunes today! Download now.
Need Benson’s Microbiological Applications Lab Manual in PDF format? Access it easily on VirtualPM.net! Perfect for students & professionals. Download today!
Navigating the world of Virtual Project Management? Our EZ66 Guide breaks down everything you need to know – from tools to techniques. Let’s get your projects soaring!
Download the Fast Metabolism Diet Cookbook PDF & kickstart your journey to a healthier you! Delicious recipes & a plan to boost your metabolism. Get it now!
Unlock stunning designs! Download the ‘Graphic Design New Basics’ PDF & master essential principles. Perfect for beginners & pros – boost your creativity now!
Struggling with survivor’s guilt? Find clarity & practical coping strategies in this free PDF. Explore the emotional toll & begin your journey to healing today!
Ace your fire instructor certification! Download the official NFPA 1041 PDF & unlock expert training techniques. VirtualPM.net has the resources you need to succeed.